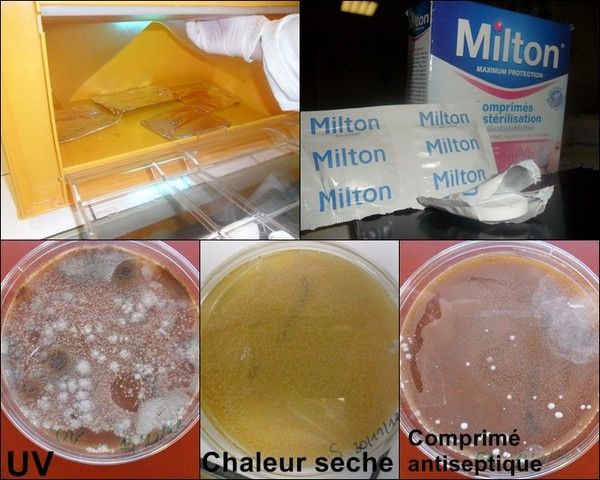
D'autres méthodes de stérilisation

société sortie recherches homme papier nature
RechercherArticles les plus lus· Comment sont aseptisées les chambres dite stériles ?
· Les conséquences médicales d'une mauvaise stérilisation
· Conclusion
· La stérilisation qu'est ce que c'est ?
· Démonstration de l'utilité de la stérilisation
· La stérilisation à la vapeur
· D'autres méthodes de stérilisation
· Introduction
· Présentation
· II) Les différentes techniques de stérilisations
· I) La stérilisation
· Pourquoi on l'utilise en milieu médical ?
· À notre CHA"
· Remerciements
Date de création : 25.01.2013
Dernière mise à jour :
17.03.2013
14 articles
D'autres méthodes de stérilisation
De manière à mieux approfondir notre sujet nous avons décidé de tester différentes techniques de stérilisation que nous avons découvert pendant nos recherches. Et nous nous somme ainsi demandé s'il y avait une différence dans leur efficacité.
Après réflexion nous avons décidé de réaliser la même expérience de mise en culture de levures mais en variant les techniques. C'est à dire que nous avons tenté de stériliser les outils aux UV, à la chaleur sèche et aux comprimés antiseptiques.
Pour toute les techniques nous avons tout d'abord lavé au savon et à l'alcool les instruments, que nous avons ensuite emballés individuellement dans du papier aluminium suivant le pliage de l'enveloppe que nous avons appris lors de notre sortie (sauf pour les comprimés antiseptiques)
Ainsi pour les uv nous avons passé les instruments pendant 45 min dans une cabine prévue à cet effet. Puis pour la technique à chaleur sèche, nous avons tout placé dans un four poupinel pendant également 45 minutes. Pour finir nous avons stérilisé grâce aux comprimés antiseptique habituellement utilisés pour les biberons, et nous avons suivi les instructions au dos de la boite, nous avons donc immergé les pipettes et râteaux pendant 20 minutes dans une solution aqueuse de dichloroisocyanurate de sodium.
Nous avons ensuite remis en culture des levures dans des boites de pétrie comme précédemment mais en utilisant les objets que l'on a utilisés, ainsi nous avons attendu trois semaines pour pouvoir observer les résultats de nos expériences et finalement nous avons pu les comparer afin de savoir laquelle de ces méthodes était la plus efficace.
On constate donc que la technique la plus efficace est la stérilisation à la chaleur sèche, car on ne voit aucun champignon dans la boite de pétrie. De plus on ne voit également aucun champignon dans la boite de pétrie ou les levures était mise en culture avec les objets stérilisés pas les comprimés antiseptiques. Cependant on remarque que la stérilisation aux UV elle n'est pas vraiment efficace puisque beaucoup de champignons se sont développés dans la boite de pétrie.
D’après nos observations on peut en déduire que dans les procèdes de stérilisation il en existe des plus ou moins efficaces, en effet la stérilisation à la chaleur sèche et les comprimées antiseptiques sont bien plus efficaces que les uv par exemple et sont utilisés pour le bien être et la santé de l'homme contrairement au UV qui sont une technique beaucoup moins efficace et de ce fait on l'utilise uniquement pour les aquariums ou les piscines. De plus certaines méthodes de stérilisation sont plus nocives pour la santé que d'autres comme on la vu précédemment ce qui en fait des techniques beaucoup moins efficaces puisqu'elles augmentent les risques de maladies au lieux de les réduire.